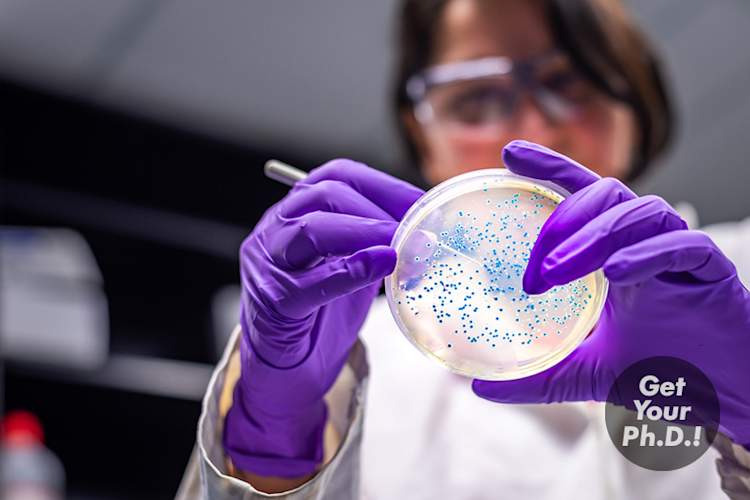
用贴纸微生物实验室

蒙娜丽莎Rezapour,医学博士
医疗审阅Rezapour博士出席加州大学伯克利分校和分子生物学环境与专业。然后,她完成了她在生殖和癌症生物学健康科学大师在布隆博格公共卫生学院。她获得医学学位的医学院约翰霍普金斯大学医学院,并完成了她的实习和在南加州大学居住在内科。然后,她完成了她的胃肠病学奖学金在美国加州太平洋医疗中心在旧金山。跟随她的奖学金培训,她搬到了佛罗里达州迈阿密大学完成炎症性肠病先进的奖学金。Rezapour博士的临床兴趣包括炎性肠道疾病。她在胃肠道蠕动及功能性疾病的专门培训。
最新由蒙娜丽莎Rezapour,医学博士

刚确诊为丙型肝炎?这是你的下一步
知道如何从诊断和检测丙型肝炎做治疗和超越。
拜见研究人员正在努力改变UC的未来
有很多令人兴奋的科学,现在发生的事情,所有的带来了新的和更加有效的治疗方法,以人与溃疡性结肠炎的目标。我们聊了一些在该领域的顶级文档,为您带来最新的。

让我们来谈谈丙型肝炎
阅读在当做我们的专家帮助我们在丙型肝炎病因,症状,治疗和许多其他事实和技巧,可以使与丙肝的生活轻松了许多零。

8种方法睡得更好溃疡性结肠炎
如果你住溃疡性结肠炎(UC),睡眠可能不容易。崩溃浴室地板的短,你能做些什么来帮助?试试这些专家的战略。

补充溃疡性结肠炎:你应该怎么走?
溃疡性结肠炎会影响你的身体吸收养分的能力,但弹出真的有必要多丸?以下是如何找到答案。

伤心?强调?如何与UC的情感代价应对
对于与(常常被忽视),具有溃疡性结肠炎的情感代价应对10留强的战略。

你应该知道的关于溃疡性结肠炎和眼睛健康
引起炎症UC可以影响比你的消化道多。通过看出来溃疡性结肠炎相关的这些常见的眼部健康状况保护您的视力。

让我们来谈谈克罗恩病的症状
想知道如果你的不满直觉可能是一些更严重的迹象?以下是如何知道它的时候,看到一个文档。

让我们来谈谈溃疡性结肠炎的药物
无论你的症状轻微,严重,或介于两者之间,有你就能够找到一种药物,可以帮助您治愈的好机会。

